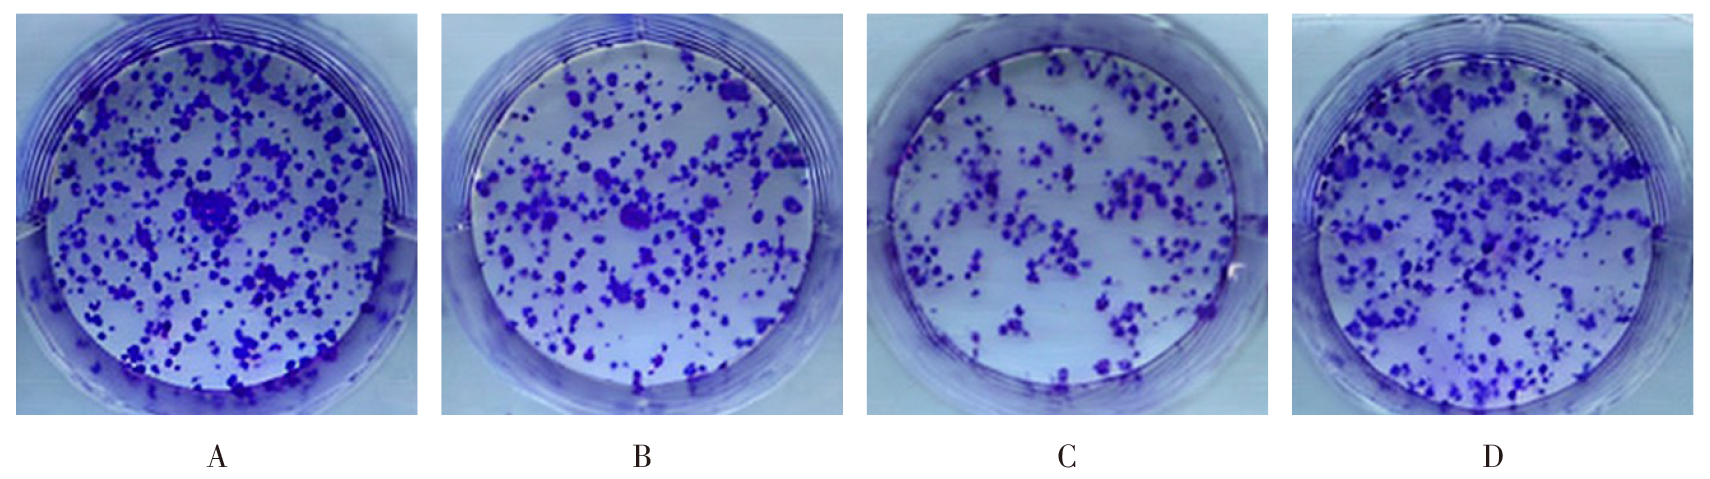

天津医药 ›› 2025, Vol. 53 ›› Issue (12): 1233-1240.doi: 10.11958/20252587
• 细胞与分子生物学 • 下一篇
收稿日期:2025-07-25
修回日期:2025-08-28
出版日期:2025-12-15
发布日期:2025-12-08
作者简介:谢银冬(1988),女,主治医师,主要从事临床麻醉学方面研究。E-mail:基金资助:
XIE Yindong( ), ZHOU Ying, LI Yanping, NIU Yajing, SU Qichao
), ZHOU Ying, LI Yanping, NIU Yajing, SU Qichao
Received:2025-07-25
Revised:2025-08-28
Published:2025-12-15
Online:2025-12-08
谢银冬, 周颖, 李艳平, 牛亚静, 苏启超. 右美托咪定调控CCL2-CCR2通路对胆囊癌细胞生物学行为的影响[J]. 天津医药, 2025, 53(12): 1233-1240.
XIE Yindong, ZHOU Ying, LI Yanping, NIU Yajing, SU Qichao. The effect of dexmedetomidine on the biological behavior of gallbladder cancer cells by regulating the CCL2-CCR2 pathway[J]. Tianjin Medical Journal, 2025, 53(12): 1233-1240.
摘要:
目的 探索右美托咪定调控C-C趋化因子配体2(CCL2)-C-C趋化因子受体2(CCR2)通路对胆囊癌细胞增殖、侵袭和细胞周期的影响。方法 将GBC-SD细胞分为对照组、右美托咪定低浓度(2 μmol/L)组、右美托咪定高浓度(4 μmol/L)组、右美托咪定高浓度+CCL2组(4 μmol/L右美托咪定和10 μg/L CCL2蛋白);克隆形成实验和Edu实验测定细胞增殖;Transwell实验测定细胞侵袭和迁移;流式细胞术测定细胞周期和凋亡;Western blot测定增殖细胞核抗原(PCNA)、细胞周期蛋白D1(CyclinD1)、基质金属蛋白酶(MMP)-2、MMP-9、Bcl-2相关X蛋白(Bax)、胱天蛋白酶-3(Caspase-3)、CCL2、CCR2蛋白表达;裸鼠移植瘤实验观察胆囊癌移植瘤生长情况。结果 低、高浓度右美托咪定处理后,克隆形成数、Edu阳性率、侵袭及迁移数下降,PCNA、CyclinD1、MMP-2、MMP-9、CCL2及CCR2蛋白表达量降低,G2/M期、S期细胞比例减少,G0/G1期细胞比例、细胞凋亡率及Bax、Caspase-3蛋白表达量升高,且高浓度右美托咪定的效果更明显(P<0.05);右美托咪定对胆囊癌细胞增殖、侵袭、迁移和细胞周期的抑制作用及对细胞凋亡的促进作用可被CCL2蛋白所逆转(P<0.05);体内实验显示,右美托咪定可降低裸鼠肿瘤质量、肿瘤体积及肿瘤组织CCL2、CCR2蛋白表达量(P<0.05)。结论 右美托咪定通过抑制CCL2-CCR2通路抑制胆囊癌细胞增殖、侵袭,并将细胞周期阻滞在G0/G1期。
中图分类号:
图1 各组细胞克隆形成实验的结晶紫染色结果 A:对照组;B:右美托咪定低浓度组;C:右美托咪定高浓度组;D:右美托咪定高浓度+CCL2组。图2—8同。
Fig.1 The crystal violet staining results of cell clone formation experiments in each group
| 组别 | 克隆形成数/个 | Edu阳性细胞率/% | ||
|---|---|---|---|---|
| 对照组 | 192.63±17.14 | 45.18±4.93 | ||
| 右美托咪定低浓度组 | 141.78±13.52a | 31.84±3.64a | ||
| 右美托咪定高浓度组 | 84.25±9.81ab | 17.76±2.06ab | ||
| 右美托咪定高浓度+CCL2组 | 170.04±15.49c | 39.52±4.38c | ||
| F | 64.745** | 55.510** | ||
| 组别 | PCNA | CyclinD1 | ||
| 对照组 | 1.31±0.14 | 1.02±0.11 | ||
| 右美托咪定低浓度组 | 0.96±0.11a | 0.64±0.07a | ||
| 右美托咪定高浓度组 | 0.43±0.05ab | 0.31±0.03ab | ||
| 右美托咪定高浓度+CCL2组 | 1.18±0.12c | 0.87±0.09c | ||
| F | 74.305** | 88.185** | ||
表1 各组细胞克隆形成数、Edu阳性细胞率及PCNA、CyclinD1蛋白表达比较
Tab.1 Comparison of clone formation numbers, Edu-positive cell rates and protein expressions of PCNA and CyclinD1 between four groups of cells (n=6,$ \bar{x} \pm s$)
| 组别 | 克隆形成数/个 | Edu阳性细胞率/% | ||
|---|---|---|---|---|
| 对照组 | 192.63±17.14 | 45.18±4.93 | ||
| 右美托咪定低浓度组 | 141.78±13.52a | 31.84±3.64a | ||
| 右美托咪定高浓度组 | 84.25±9.81ab | 17.76±2.06ab | ||
| 右美托咪定高浓度+CCL2组 | 170.04±15.49c | 39.52±4.38c | ||
| F | 64.745** | 55.510** | ||
| 组别 | PCNA | CyclinD1 | ||
| 对照组 | 1.31±0.14 | 1.02±0.11 | ||
| 右美托咪定低浓度组 | 0.96±0.11a | 0.64±0.07a | ||
| 右美托咪定高浓度组 | 0.43±0.05ab | 0.31±0.03ab | ||
| 右美托咪定高浓度+CCL2组 | 1.18±0.12c | 0.87±0.09c | ||
| F | 74.305** | 88.185** | ||
| 组别 | 侵袭数/个 | 迁移数/个 | ||
|---|---|---|---|---|
| 对照组 | 126.83±15.14 | 142.32±16.38 | ||
| 右美托咪定低浓度组 | 71.45±8.57a | 87.17±9.84a | ||
| 右美托咪定高浓度组 | 32.72±4.13ab | 41.45±4.66ab | ||
| 右美托咪定高浓度+CCL2组 | 110.24±12.36c | 123.06±14.24c | ||
| F | 89.792** | 80.139** | ||
| 组别 | MMP-2 | MMP-9 | ||
| 对照组 | 1.36±0.13 | 1.25±0.13 | ||
| 右美托咪定低浓度组 | 0.91±0.10a | 0.78±0.08a | ||
| 右美托咪定高浓度组 | 0.48±0.05ab | 0.33±0.04ab | ||
| 右美托咪定高浓度+CCL2组 | 1.21±0.13c | 1.04±0.11c | ||
| F | 78.065** | 101.924** | ||
表2 各组细胞侵袭、迁移数及MMP-2、MMP-9蛋白表达比较
Tab.2 Comparison of invasion and migration numbers, expression levels of MMP-2 and MMP-9 proteins between four groups of cells (n=6,$ \bar{x} \pm s$)
| 组别 | 侵袭数/个 | 迁移数/个 | ||
|---|---|---|---|---|
| 对照组 | 126.83±15.14 | 142.32±16.38 | ||
| 右美托咪定低浓度组 | 71.45±8.57a | 87.17±9.84a | ||
| 右美托咪定高浓度组 | 32.72±4.13ab | 41.45±4.66ab | ||
| 右美托咪定高浓度+CCL2组 | 110.24±12.36c | 123.06±14.24c | ||
| F | 89.792** | 80.139** | ||
| 组别 | MMP-2 | MMP-9 | ||
| 对照组 | 1.36±0.13 | 1.25±0.13 | ||
| 右美托咪定低浓度组 | 0.91±0.10a | 0.78±0.08a | ||
| 右美托咪定高浓度组 | 0.48±0.05ab | 0.33±0.04ab | ||
| 右美托咪定高浓度+CCL2组 | 1.21±0.13c | 1.04±0.11c | ||
| F | 78.065** | 101.924** | ||
| 组别 | G0/G1期 | G2/M期 | S期 |
|---|---|---|---|
| 对照组 | 26.18±2.93 | 24.74±2.81 | 49.08±5.02 |
| 右美托咪定低浓度组 | 41.42±4.71a | 16.85±1.84a | 41.73±4.32a |
| 右美托咪定高浓度组 | 54.83±5.90ab | 11.26±1.42ab | 33.91±3.27ab |
| 右美托咪定高浓度+CCL2组 | 33.25±3.67c | 21.57±2.58c | 45.18±5.01c |
| F | 45.930** | 41.478** | 12.540** |
表3 各组细胞G0/G1期、G2/M期、S期细胞比例比较
Tab.3 Comparison of proportions of cells in G0/G1 phase, G2/M phase and S phase between four groups of cells (n=6,%,$ \bar{x} \pm s$)
| 组别 | G0/G1期 | G2/M期 | S期 |
|---|---|---|---|
| 对照组 | 26.18±2.93 | 24.74±2.81 | 49.08±5.02 |
| 右美托咪定低浓度组 | 41.42±4.71a | 16.85±1.84a | 41.73±4.32a |
| 右美托咪定高浓度组 | 54.83±5.90ab | 11.26±1.42ab | 33.91±3.27ab |
| 右美托咪定高浓度+CCL2组 | 33.25±3.67c | 21.57±2.58c | 45.18±5.01c |
| F | 45.930** | 41.478** | 12.540** |
| 组别 | 细胞凋亡率/% | Bax | Caspase-3 |
|---|---|---|---|
| 对照组 | 3.06±0.45 | 0.74±0.08 | 0.48±0.05 |
| 右美托咪定低浓度组 | 15.36±2.12a | 1.23±0.16a | 0.85±0.09a |
| 右美托咪定高浓度组 | 32.97±3.84ab | 1.68±0.19ab | 1.36±0.15ab |
| 右美托咪定高浓度+ CCL2组 | 9.14±1.42c | 0.92±0.10c | 0.61±0.07c |
| F | 186.359** | 52.044** | 95.179** |
表4 各组细胞凋亡率及Bax、Caspase-3蛋白表达比较
Tab.4 Comparison of apoptosis rates and protein expression of Bax and Caspase-3 between four groups of cells (n=6,$ \bar{x} \pm s$)
| 组别 | 细胞凋亡率/% | Bax | Caspase-3 |
|---|---|---|---|
| 对照组 | 3.06±0.45 | 0.74±0.08 | 0.48±0.05 |
| 右美托咪定低浓度组 | 15.36±2.12a | 1.23±0.16a | 0.85±0.09a |
| 右美托咪定高浓度组 | 32.97±3.84ab | 1.68±0.19ab | 1.36±0.15ab |
| 右美托咪定高浓度+ CCL2组 | 9.14±1.42c | 0.92±0.10c | 0.61±0.07c |
| F | 186.359** | 52.044** | 95.179** |
| 组别 | CCL2 | CCR2 |
|---|---|---|
| 对照组 | 1.16±0.12 | 1.21±0.13 |
| 右美托咪定低浓度组 | 0.81±0.09a | 0.89±0.10a |
| 右美托咪定高浓度组 | 0.57±0.06ab | 0.62±0.07ab |
| 右美托咪定高浓度+CCL2组 | 0.99±0.10c | 1.08±0.11c |
| F | 42.432** | 35.900** |
表5 各组细胞CCL2、CCR2蛋白表达比较
Tab.5 Comparison of CCL2 and CCR2 protein expression between four groups of cells (n=6,$ \bar{x} \pm s$)
| 组别 | CCL2 | CCR2 |
|---|---|---|
| 对照组 | 1.16±0.12 | 1.21±0.13 |
| 右美托咪定低浓度组 | 0.81±0.09a | 0.89±0.10a |
| 右美托咪定高浓度组 | 0.57±0.06ab | 0.62±0.07ab |
| 右美托咪定高浓度+CCL2组 | 0.99±0.10c | 1.08±0.11c |
| F | 42.432** | 35.900** |
| 组别 | 体质量/g | 肿瘤质量/g | |||
|---|---|---|---|---|---|
| 对照组 | 23.12±2.43 | 0.61±0.06 | |||
| 右美托咪定组 | 22.76±2.30 | 0.34±0.04 | |||
| t | 0.340 | 11.840** | |||
| 组别 | 肿瘤体积/mm3 | CCL2 | CCR2 | ||
| 对照组 | 1 361.85±57.28 | 0.93±0.10 | 0.87±0.09 | ||
| 右美托咪定组 | 967.46±40.12 | 0.45±0.05 | 0.41±0.04 | ||
| t | 17.834** | 13.576** | 14.770** | ||
表6 2组裸鼠体质量、肿瘤质量、肿瘤体积及CCL2、CCR2蛋白表达比较
Tab.6 Comparison of body weight, tumor mass, tumor volume and expression levels of CCL2 and CCR2 proteins between four groups of nude mice (n=10,$ \bar{x} \pm s$)
| 组别 | 体质量/g | 肿瘤质量/g | |||
|---|---|---|---|---|---|
| 对照组 | 23.12±2.43 | 0.61±0.06 | |||
| 右美托咪定组 | 22.76±2.30 | 0.34±0.04 | |||
| t | 0.340 | 11.840** | |||
| 组别 | 肿瘤体积/mm3 | CCL2 | CCR2 | ||
| 对照组 | 1 361.85±57.28 | 0.93±0.10 | 0.87±0.09 | ||
| 右美托咪定组 | 967.46±40.12 | 0.45±0.05 | 0.41±0.04 | ||
| t | 17.834** | 13.576** | 14.770** | ||
| [1] | HE J J, XIONG W L, SUN W Q, et al. Advances and current research status of early diagnosis for gallbladder cancer[J]. Hepatobiliary Pancreat Dis Int, 2025, 24(3):239-251. doi:10.1016/j.hbpd.2024.09.011. |
| [2] | CHAI C, TANG H, MIAO X, et al. Establishment and characterization of a novel human gallbladder cancer cell line, GBC-X1[J]. Sci Rep, 2024, 14(1):21439. doi:10.1038/s41598-024-72830-0. |
| [3] | ZHAO C, ZHANG J, YANG Z Y, et al. Ponicidin inhibited gallbladder cancer proliferation and metastasis by decreasing MAGEB2 expression through FOXO4[J]. Phytomedicine, 2023,114:154785. doi:10.1016/j.phymed.2023.154785. |
| [4] | CARNET L E PROVOST K, KEPP O, KROEMER G, et al. Trial watch:dexmedetomidine in cancer therapy[J]. Oncoimmunology, 2024, 13(1):2327143. doi:10.1080/2162402X.2024.2327143. |
| [5] | ZHANG P, HE H, BAI Y, et al. Dexmedetomidine suppresses the progression of esophageal cancer via miR-143-3p/epidermal growth factor receptor pathway substrate 8 axis[J]. Anticancer Drugs, 2020, 31(7):693-701. doi:10.1097/CAD.0000000000000934. |
| [6] | XU M, WANG Y, XIA R, et al. Role of the CCL2-CCR2 signalling axis in cancer:mechanisms and therapeutic targeting[J]. Cell Prolif, 2021, 54(10):e13115. doi:10.1111/cpr.13115. |
| [7] | ESLAMI M, AZIZI JALILIAN F, NAJAFI R, et al. Promising modulatory effects of cenicriviroc on the progression of mouse colorectal cancer through inhibition of CCR2_CCL2 signaling pathway[J]. Evid Based Complement Alternat Med, 2023,2023:5993866. doi:10.1155/2023/5993866. |
| [8] | 江帆, 谢柯祺. 布托啡诺调节CCL2-CCR2轴对食管癌细胞增殖、凋亡和迁移的影响[J]. 临床外科杂志, 2024, 32(2):168-172. |
| JIANG F, XIE K Q. Impacts of butorphanol on the proliferation,apoptosis and migration of esophageal cancer cells by regulating CCL2-CCR2 axis[J]. Journal of Clinical Surgery, 2024, 32(2):168-172. doi:10.3969/j.issn.1005-6483.2024.02.013. | |
| [9] | 吴瑞欣, 周大臣, 唐赛兰, 等. 右美托咪定对肝细胞肝癌肿瘤学行为的影响及Nrf2在其中的作用[J]. 安徽医科大学学报, 2024, 59(1):15-22. |
| WU R X, ZHOU D C, TANG S L, et al. Effects of dexmedetomidine on the oncological behavior of hepatocellular carcinoma and role of Nrf2[J]. Acta Universitatis Medicinalis Anhui, 2024, 59(1):15-22. doi:10.19405/j.cnki.issn1000-1492.2024.01.003. | |
| [10] | HE H, CHEN S, YU Y, et al. Comprehensive single-cell analysis deciphered microenvironmental dynamics and immune regulator olfactomedin 4 in pathogenesis of gallbladder cancer[J]. Gut, 2024, 73(9):1529-1542. doi:10.1136/gutjnl-2023-331773. |
| [11] | SONG X, HU Y, LI Y, et al. Overview of current targeted therapy in gallbladder cancer[J]. Signal Transduct Target Ther, 2020, 5(1):230. doi:10.1038/s41392-020-00324-2. |
| [12] | YIN Z, CHEN T, SHU Y, et al. A gallbladder cancer survival prediction model based on multimodal fusion analysis[J]. Dig Dis Sci, 2023, 68(5):1762-1776. doi:10.1007/s10620-022-07782-4. |
| [13] | CHO J S, SEON K, KIM M Y, et al. Effects of perioperative dexmedetomidine on immunomodulation in uterine cancer surgery:a randomized, controlled trial[J]. Front Oncol, 2021,11:749003. doi:10.3389/fonc.2021.749003. |
| [14] | ZHANG W, ZHANG L, CAI X J, et al. Dexmedetomidine inhibits the growth and metastasis of esophageal cancer cells by down-regulation of lncRNA MALAT1[J]. Kaohsiung J Med Sci, 2022, 38(6):585-593. doi:10.1002/kjm2.12506. |
| [15] | GAO X, WANG X L. Dexmedetomidine promotes ferroptotic cell death in gastric cancer via hsa_circ_0008035/miR-302a/E2F7 axis[J]. Kaohsiung J Med Sci, 2023, 39(4):390-403. doi:10.1002/kjm2.12650. |
| [16] | HAO Q, VADGAMA J V, WANG P. CCL2/CCR2 signaling in cancer pathogenesis[J]. Cell Commun Signal, 2020, 18(1):82. doi:10.1186/s12964-020-00589-8. |
| [17] | YANG H, ZHANG Q, XU M, et al. CCL2-CCR2 axis recruits tumor associated macrophages to induce immune evasion through PD-1 signaling in esophageal carcinogenesis[J]. Mol Cancer, 2020, 19(1):41. doi:10.1186/s12943-020-01165-x. |
| [18] | TU W, GONG J, ZHOU Z, et al. TCF4 enhances hepatic metastasis of colorectal cancer by regulating tumor-associated macrophage via CCL2/CCR2 signaling[J]. Cell Death Dis, 2021, 12(10):882. doi:10.1038/s41419-021-04166-w. |
| [19] | YANG Z, LI H, WANG J, et al. CCL2/CCR2 axis promotes perineural invasion of salivary adenoid cystic carcinoma via ITGβ5-mediated nerve-tumor interaction[J]. Biochim Biophys Acta Mol Basis Dis, 2025, 1871(1): 167484. doi:10.1016/j.bbadis.2024.167484. |
| [1] | 杨晓芳, 贾新燕, 丰文君. miR-181a-5p通过HMGB1/NF-κB信号通路调控狼疮性肾炎小鼠肾小球系膜细胞增殖和凋亡[J]. 天津医药, 2026, 54(3): 232-237. |
| [2] | 王喆, 邱林, 马贲. 番茄来源胞外囊泡样颗粒对口腔鳞状细胞癌的作用效果研究[J]. 天津医药, 2026, 54(2): 145-150. |
| [3] | 赵兰君, 李良惠, 马馨, 巩娇娇, 郑臣辉, 石琳. 穿心莲内酯调控STAT3/GPX4通路对骨髓瘤细胞增殖和凋亡的影响[J]. 天津医药, 2026, 54(1): 8-13. |
| [4] | 刘虹, 张玥玥, 王一琳, 王彩丽, 王晓敏, 毛敏, 李燕. MicroRNA-34a通过调控Wnt途径影响慢性淋巴细胞白血病进展的机制探讨[J]. 天津医药, 2025, 53(8): 785-790. |
| [5] | 韩建存, 周谊. 川陈皮素调节FAK/AKT信号通路对喉鳞状细胞癌细胞增殖和凋亡的影响[J]. 天津医药, 2025, 53(6): 561-565. |
| [6] | 余朝霞, 马贲, 邱林, 高倩, 尼娜. 基于网络药理学和实验验证探究鲍式层孔菌多酚的抗头颈鳞癌机制[J]. 天津医药, 2025, 53(5): 456-461. |
| [7] | 李晨, 李占恩, 苏宏伟, 侯彩云, 董少文. KRT17调节Wnt/β-catenin信号通路对膀胱癌细胞增殖、凋亡及上皮间质转化的影响[J]. 天津医药, 2025, 53(5): 462-467. |
| [8] | 苏红见, 张春艳, 张卫东, 韩利, 乔亚红. 鸢尾素调控EBF3/ALOX15通路影响肺腺癌细胞增殖和迁移[J]. 天津医药, 2025, 53(4): 337-342. |
| [9] | 祁卫华, 黄广磊, 张媛媛, 班宏英, 毛诏旭. 连翘脂素调节cAMP/EPAC1/RAP1信号通路对肺癌细胞恶性进展的影响[J]. 天津医药, 2025, 53(4): 343-348. |
| [10] | 闫玲新, 李森, 郭改莉, 孟婉秋, 徐超. 异牡荆素通过miR-339-5p/HSPA8轴调节胰腺癌细胞的生物学行为[J]. 天津医药, 2025, 53(3): 230-235. |
| [11] | 马莉莉, 李子沐, 王亮, 许彭, 李秀梅. 间充质干细胞外泌体对食管癌ECA109细胞生物学行为的影响[J]. 天津医药, 2025, 53(2): 113-117. |
| [12] | 王健, 程宪永, 于宁. miR-1247-5p/Smad2轴对胃癌细胞迁移、侵袭和上皮间质转化的影响[J]. 天津医药, 2025, 53(2): 118-123. |
| [13] | 杨健, 李敏, 李越洋, 田晨. T-ALL来源的骨髓基质细胞通过FGF2-FGFR2通路促进T-ALL增殖[J]. 天津医药, 2025, 53(1): 29-34. |
| [14] | 高蕊, 周官恩, 洪雁, 颜艳. 蛋白酪氨酸磷酸酶受体R型对胶质瘤细胞恶性生物学行为的影响[J]. 天津医药, 2025, 53(1): 9-13. |
| [15] | 张晋玮, 王燕, 王通. miR-107对口腔鳞癌细胞系CAL27增殖、侵袭及迁移的影响[J]. 天津医药, 2024, 52(9): 897-899. |
| 阅读次数 | ||||||
|
全文 |
|
|||||
|
摘要 |
|
|||||